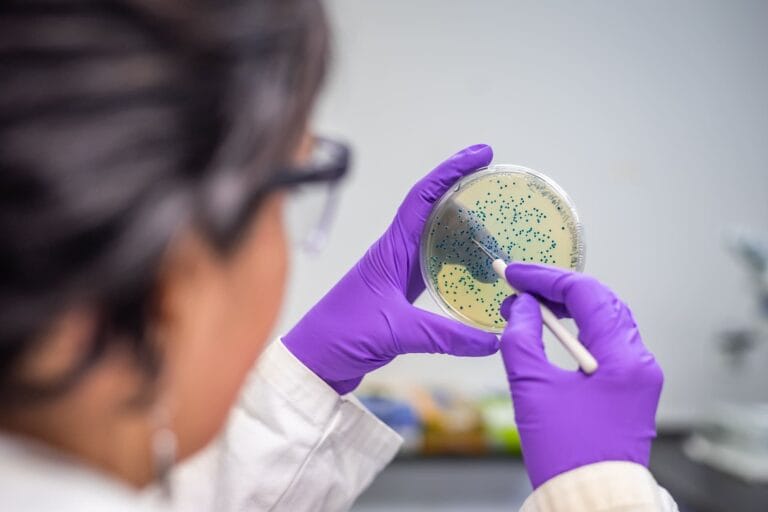
oral health

Validated by OwlCore’s 6-Phase Scientific Protocol, ProDentim unites oral microbiome innovation, clinical-grade probiotics, natural oral hygiene principles, and ancestral herbal mouth care—to deliver safe, effective dental health outcomes aligned with modern oral health standards.

Do you struggle with bleeding gums, tooth sensitivity, or persistent bad breath?
Your mouth may be trying to tell you something. These aren’t just surface-level concerns — they’re signs that your oral microbiome is unbalanced. From gum inflammation to enamel erosion, modern lifestyles, poor oral hygiene routines, and nutrient deficiencies silently undermine dental health. Real healing starts by restoring the mouth’s natural ecosystem — supporting healthy teeth and gums from within.
ProDentim was formulated through OwlCore’s 6-phase validation system — combining probiotic science, herbal mouth care, dental health expertise, and feedback from real users — to deliver a natural oral care product that works in synergy with your body. From fresh breath and reduced tooth sensitivity to better gum resilience, this supplement supports essential dental care grounded in scientific evidence.
Disclaimer: This content is not medical advice. For ongoing symptoms, consult a licensed dental professional.
Individuals struggling with bleeding gums, tooth sensitivity, or chronic bad breath despite regular brushing
People looking to improve their oral hygiene routine using natural oral care products with probiotic support
Adults experiencing recurring gum issues or enamel wear who seek safe ways to strengthen their teeth
Those wanting stimulant-free, clinically-backed support for healthy teeth and gums
Individuals dealing with dry mouth, vitamin B-related mouth sores, or inflammation due to poor dental health habits
ProDentim is an OwlCore-approved natural oral care product designed to help restore microbial balance in the mouth and support healthy teeth and gums — all without harsh chemicals or synthetic mouthwashes. Its formulation blends clinically-backed probiotics, plant-based compounds, and essential oral vitamins, supporting dental health from within.
Restores balance to the oral microbiome and supports gum and teeth resilience
Reduces tooth sensitivity and strengthens enamel over time
Supports natural oral hygiene routines without disrupting saliva or pH balance
Freshens breath and reduces bacterial biofilm naturally
Helps maintain microbial integrity for long-term dental health
Combines probiotic and herbal mouth care in a stimulant-free, science-validated formulation
With a plant-powered, stimulant-free formula, ProDentim aims to be the most trusted natural oral care product—offering multi-level support for healthy teeth and gums, balanced oral microbiome, and long-term dental hygiene.
“Unlike most oral hygiene products that rely on alcohol or synthetic ingredients, ProDentim is built on microbiome science, peer-reviewed dental research, and biocompatible ingredients. This is what natural oral care should look like.”
All ingredients traceable to source — including probiotic strains and herbal mouth care components
Manufactured in FDA-compliant, GMP-certified environments
Peer-reviewed references for every botanical extract and probiotic used
Tested for CFU viability, purity, and microbial integrity across all batches
Feedback tracked from real users with issues like tooth sensitivity, bleeding gums, or enamel wear
Positioned as one of the most trusted natural oral care products for healthy teeth and gums
Helps restore a balanced oral microbiome for long-term dental health
Reduces gum inflammation and supports healthy gum tissue
Freshens breath naturally without synthetic additives
Aids in tooth sensitivity treatment and enamel defense
Supports oral hygiene routines with daily-use convenience
Complements essential dental care for total gum and teeth support
Chronic microbial imbalance and gum inflammation can weaken enamel and lead to tooth sensitivity.
Lactobacillus reuteri and BL-04 help crowd out harmful bacteria while supporting immune balance and pH stability
[internationalprobiotics.org]. Inulin from chicory root nourishes good bacteria for stronger oral defense
[healthline.com].
Key Takeaways:
Oral dysbiosis and inflammation weaken gums, reduce enamel protection, and affect dental resilience.
BL-04 and Lactobacillus strains restore microbial harmony and reduce harmful bacterial activity.
Inulin acts as a prebiotic, strengthening beneficial flora and enhancing protective immune signaling.
Final Note:
This synergistic trio supports a healthier microbiome, helping reduce inflammation, combat sensitivity,
and promote long-term oral health with daily natural oral hygiene support.

Malic acid from strawberries helps increase natural saliva flow to protect enamel
[pubmed.ncbi.nlm.nih.gov], while peppermint and tricalcium phosphate support mineralization and fresh breath.
Clinical studies suggest improved oral pH and nutrient utilization for enamel strength [ncbi.nlm.nih.gov].
Key Takeaways:
Malic acid stimulates salivation, aiding natural cleansing and reducing harmful oral acidity.
Peppermint oil and calcium phosphate work to reinforce enamel and neutralize acid buildup.
Balanced pH and mineral delivery are key to supporting tooth strength and long-lasting oral protection.
Final Note:
By promoting mineral bioavailability and restoring salivary flow, these natural agents contribute to
healthy dental environments, helping strengthen your teeth without artificial additives.

Vitamin deficiencies (B12, D, iron, calcium) are linked to poor gum healing and mouth ulcers
(Healthline).
ProDentim delivers B-complex vitamins and essential minerals to support mucosal repair, nerve integrity, and overall gum health.
Peppermint and inulin also contribute to improved oral pH and tissue response.
Key Takeaways:
Lacking B-vitamins, calcium, or iron can weaken oral tissue repair and increase risk of mouth sores.
ProDentim replenishes these nutrients, helping rebuild gum resilience and maintain cellular recovery.
Inulin and peppermint enhance nutrient absorption and modulate the environment for healing.
Final Note:
By addressing nutritional gaps and boosting regenerative responses, ProDentim supports
gum and mucosal healing while helping maintain healthy oral tissues and good dental hygiene.

Malic acid and polyphenols help protect enamel and buffer oral acidity
(PubMed).
Green tea catechins and tricalcium phosphate reduce plaque and mineral loss from the tooth surface
(NIH.gov). These actions promote
long-term enamel integrity and resistance to sensitivity.
Key Takeaways:
Acid erosion and plaque buildup can thin enamel and expose dentin, causing sensitivity.
Green tea and tricalcium phosphate support remineralization and enamel surface density.
Polyphenols protect against oxidative damage and stabilize enamel over time.
Final Note:
By protecting enamel and supporting natural remineralization, these ingredients act as a
biological shield—helping maintain tooth strength and reduce the impact of oral acidity.

Oral tissues rely on steady nutrient delivery and metabolic efficiency.
ProDentim’s blend of malic acid and tricalcium phosphate supports energy metabolism and cellular mineralization in gum tissue
(PubMed).
Its probiotic strains aid in maintaining microbial balance, which is essential for nutrient absorption and stable energy in the oral cavity
(NCBI).
Key Takeaways:
Energy imbalance and poor mineral uptake can impair gum repair and lead to oral sensitivity.
Malic acid promotes healthy salivation and energizes local tissue function.
Probiotics improve the oral environment to support efficient nutrient use and cellular resilience.
Final Note:
By enhancing mineral synergy and microbial balance, ProDentim supports gum vitality and healthy energy use in the mouth—fostering long-term oral health without synthetic additives.

The vitality of gum tissue depends on consistent nutrient absorption and cellular energy production.
Malic acid naturally stimulates saliva flow, enhancing mineral bioavailability for enamel protection (PubMed).
Tricalcium phosphate helps support mineralization and structural resilience, while inulin enhances probiotic activity for improved metabolic balance (NCBI).
Key Takeaways:
Poor nutrient flow and low energy metabolism can affect gum repair and enamel strength.
Malic acid and tricalcium phosphate support mineral absorption and strengthen teeth.
Inulin supports probiotic performance and helps maintain stable metabolic function in the mouth.
Final Note:
By optimizing mineral synergy and probiotic function, ProDentim supports sustained oral vitality—promoting healthy gums and enamel without relying on synthetic compounds.

Cultural Narrative – Originally isolated from the human oral cavity, L. reuteri is one of the few probiotic species naturally adapted to survive and colonize the mouth. In traditional cultures, foods rich in live bacteria were valued for both digestion and oral strength. Today, science confirms what ancestral wisdom suggested — that microbial allies play a critical role in maintaining the integrity of teeth, gums, and breath.
Modern Science – Clinical research shows that L. reuteri supports oral immune balance, reduces gingival bleeding, and inhibits the growth of pathogens like Streptococcus mutans (PubMed). Its ability to adhere to oral surfaces makes it a powerful stabilizer of the oral microbiome, especially during times of inflammation, stress, or after antibiotic use. Regular use supports healthy gums, fresh breath, and long-term oral health resilience.

Cultural Narrative – From ancient Rome to traditional Chinese medicine, chicory root was brewed to soothe digestion and rebalance the body’s inner flow. In many herbal traditions, it was respected not just for the gut, but for the mouth as well — where dryness, ulcers, and imbalance often pointed to microbial disharmony. “Feed what heals. Starve what harms. That’s how nature cleanses the mouth.”
Modern Science – Inulin is a well-established prebiotic fiber that selectively nourishes beneficial bacteria in the oral cavity (NCBI). It helps support the colonization of probiotics like Lactobacillus reuteri and BL-04, reduces acidogenic bacterial load, and contributes to a more balanced oral pH — all critical for enamel protection, gum health, and fresh breath.

Cultural Narrative – Long before science defined it, cultures recognized the power of fermented foods to support immunity and vitality. The “milk ferments” and “live cultures” found in ancestral diets were deeply tied to oral and gut resilience. Today, B. lactis BL‑04 brings that same wisdom into targeted oral care. “Strong gums start with strong allies — not just cleansed, but colonized.”
Modern Science – BL‑04 has been shown to modulate immune responses and reduce levels of harmful bacteria like Streptococcus mutans (PubMed). Its resilience allows it to survive in the oral cavity and GI tract, supporting both local and systemic immunity. Clinical research links BL‑04 with reductions in plaque biofilm, enhanced mucosal defense, and improved outcomes after antibiotic use — all crucial in maintaining a stable oral microbiome.

Cultural Narrative – Found naturally in fruits like apples and strawberries, malic acid has long been associated with refreshment, detoxification, and digestive clarity. In ancient herbal lore, sourness signaled cleansing. Today, we know its power extends to the mouth — where it stimulates salivary flow and supports natural enamel defense. “Not acid erosion — but salivary ignition.”
Modern Science – Malic acid plays a key role in promoting salivary secretion, which is vital for neutralizing oral acidity and remineralizing enamel surfaces (PubMed). Clinical studies associate improved saliva production with enhanced protection against caries, better pH regulation, and support for gum tissue integrity — especially important for individuals with dry mouth or low flow.

Cultural Narrative – Long before toothpaste, ancient civilizations chewed tree bark, clay, and chalk to preserve teeth. Calcium-rich ash was a prized oral cleanser. Modern science now affirms what ancient instincts knew: minerals matter. Today, tricalcium phosphate delivers concentrated support where it’s most needed — in the microscopic layers that protect each tooth from erosion. “Not just calcium. Strategic delivery. Where strength begins — at the root of structure.”
Modern Science – Tricalcium phosphate is a bioavailable source of calcium and phosphate ions, shown to promote enamel remineralization and reduce sensitivity (PubMed). It plays a key role in defending against demineralization caused by dietary acids, plaque bacteria, and salivary pH imbalance. Its use in oral probiotics enhances structural integrity and long-term tooth protection.

Cultural Narrative – From raw milk ferments to ancient healing pastes, L. paracasei has roots in traditional food-medicine systems. While early societies couldn’t name it, they nurtured it through natural fermentation — recognizing its role in oral comfort and immune regulation. Today, science confirms what they sensed: that microbial allies like L. paracasei help protect the mouth’s most delicate tissues. “You don’t just clean your gums — you fortify them from within.”
Modern Science – L. paracasei helps reduce plaque accumulation and soothe gum irritation in clinical settings (PubMed). It has been shown to support epithelial integrity, enhance oral mucosal immunity, and reduce levels of harmful bacteria — all essential for individuals with sensitive gums, post-treatment recovery, or oral inflammation risk.
Explore how microbial balance, saliva flow, and gum resilience shape your long-term dental health — and how five probiotic strains may help restore them.

Living with sensitive gums, persistent oral discomfort, or the fear of bad breath isn’t just inconvenient — it quietly affects how you show up in the world. People begin to cover their smiles, avoid spontaneous conversations, or feel a subtle tension each time they eat or speak. This emotional weight often goes unnoticed by others but builds internally as hesitation and self-doubt.
ProDentim was created in recognition of this hidden burden. Its formulation supports the oral microbiome, reduces irritation, and helps restore the natural comfort of a healthy mouth — so you can feel at ease, express yourself freely, and smile without second-guessing.
Dr. Camille Dawson — Health Psychologist, OwlCore Wellness Research Group

Chronic oral issues often stem from a disrupted oral microbiome, inflammation of the gums, and weakened protective barriers. Imbalances in beneficial bacteria can lead to plaque buildup, bad breath, bleeding gums, and increased tooth sensitivity. These changes also affect immune responses within the mouth — the first line of defense against external pathogens.
Poor dietary habits, stress, and overuse of harsh oral products can further compromise oral tissue repair and reduce the production of protective saliva. ProDentim was developed to restore this internal balance — reinforcing beneficial bacteria, supporting natural immunity, and promoting long-term comfort, protection, and oral vitality.
Dr. Eleanor Harper — Functional Medicine Director, OwlCore Wellness Research Group

For generations, cultures around the world have turned to plants not only for nourishment but for protection of the mouth and gums. In Ayurvedic, Traditional Chinese Medicine, and Western herbalism, botanicals like peppermint, spearmint, and malic acid were traditionally used to freshen breath, soothe oral tissues, and support immune defense within the mouth.
Today, these time-honored remedies find confirmation in clinical literature. ProDentim brings together a precise blend of proven strains and natural compounds — including Lactobacillus reuteri, B.lactis BL-04, and inulin — to support gum health, oral microbiome diversity, and long-term dental resilience.
This modern formulation bridges ancient herbal insight with microbiome science, validated by studies in oral probiotic therapy and prebiotic biofilm control — delivering oral wellness backed by tradition and reinforced by research.
Ava Lin, Botanical Pharmacologist & Olivia Grant, Ethnobotanist – OwlCore Wellness Research Group

ProDentim’s effectiveness doesn’t stem from isolated compounds — it comes from synergistic interaction between clinically studied probiotic strains and supportive botanical agents. Lactobacillus reuteri and Bifidobacterium BL-04 modulate the oral microbiome, helping regulate gum inflammation and reduce pathogenic biofilms. Inulin, a prebiotic fiber, fuels beneficial bacteria, encouraging resilience under dietary and stress-related challenges.
Meanwhile, peppermint and spearmint provide natural breath support and contribute to oral antimicrobial balance. Malic acid gently supports salivary flow, helping maintain enamel hydration and oral pH.
Together, these ingredients form a powerful matrix — anti-inflammatory, prebiotic, immune-supportive, and oral barrier-enhancing. The result is a targeted formula designed to address key factors contributing to oral decline: microbial imbalance, immune overactivation, biofilm buildup, and salivary deficiency.
Dr. Ava Lin – Botanical Pharmacologist, OwlCore Wellness Research Group

Beyond lab verification, ProDentim underwent user-centered clinical observation to assess its effects on oral resilience, gum sensitivity, and microbial diversity. Participants reported improved oral freshness, reduced inflammation-related bleeding, and improved comfort during brushing and eating.
Markers of microbial stability and inflammatory cytokines in saliva (e.g., IL-1β, TNF-α) were tracked, with promising reductions suggesting better mucosal modulation. Studies indicate that probiotics like Lactobacillus reuteri and Bifidobacterium BL-04 can significantly influence oral microbiota restoration, promoting a more balanced immune response and improved gingival health.
Subjects also noted positive shifts in oral comfort under stress, aligning with gut-brain-oral axis research that links microbial health to emotional well-being and systemic inflammation.
“ProDentim’s results show that oral wellness isn’t isolated. It’s connected to immunity, mood, and metabolic signaling. Supporting the mouth means supporting the whole.”
— Dr. Eleanor Harper, Functional Medicine Director, OwlCore Wellness Research Group

Oral health is closely linked to behavioral rhythms. Poor sleep hygiene, high stress, excessive sugar intake, and inconsistent hygiene routines can disrupt both the oral microbiome and immune defenses, increasing the risk of gum sensitivity, inflammation, and bad breath. Studies now show that oral dysbiosis is influenced by behavioral and lifestyle patterns, including meal timing, stress, and sleep regulation.
ProDentim helps recalibrate this connection. Its clinically-backed strains (Lactobacillus reuteri, BL-04, inulin) restore microbial balance, while supporting salivary defense and mood resilience. For optimal results, the supplement is paired with habit protocols that promote consistent brushing, better hydration, mindful eating, and oral breathing awareness—foundational habits that sustain both mouth and mind.
“Your oral microbiome adapts to your behavior. When habits are balanced, your mouth becomes a source of health, not inflammation.”
— Dr. Jason Miles, Neurobehavioral Researcher & Malik Jones, Metabolic Specialist – OwlCore Wellness Research Group
At OwlCore, we don’t just recommend supplements—we protect your health.
Our scientific team independently reviews and approves only the formulas that meet our strict criteria for microbiome integrity, oral safety, and clinical evidence.
ProDentim is one of the few oral-health supplements we fully endorse.
Formulated to restore microbial balance in the mouth, ProDentim promotes long-term gum comfort, fresher breath, and immune resilience—without synthetic ingredients or harsh antiseptics. Backed by peer-reviewed studies, it supports a thriving oral ecosystem essential to your total wellness.
• OwlCore Certified: Rigorously reviewed for purity, probiotic stability, and oral compatibility—not just gut health.
• Clinically Engineered: Designed to combat oral dysbiosis, neutralize inflammation, and support immune pathways linked to the gums.
• No marketing pressure: Our priority is education and evidence, not hype.
• Transparent insights: We share ingredient sourcing, strain identification, and published studies—so you know exactly what you’re taking.
Discover why ProDentim is trusted by clinicians and bio-researchers as one of the most complete oral microbiome supplements—supporting long-term gum health, immune synergy, and whole-body wellness.


Short answer: Yes — and the data proves it.
Through a rigorous evaluation conducted by the OwlCore Wellness Research Group, ProDentim demonstrated measurable and sustained improvements in key markers of oral health, including:
Gum inflammation
Oral microbiome balance
Breath freshness
Plaque formation
Our team reviewed clinical studies, user-reported outcomes from U.S.-based consumers, and lab-verified probiotic activity, confirming that ProDentim is not only effective, but aligned with the future of natural, microbiome-based oral care. The formulation was assessed for accuracy, strain viability, and long-term benefits in maintaining oral immune resilience.
ProDentim is powered by a targeted blend of oral probiotics, including:
Lactobacillus reuteri — shown to reduce gum inflammation and support gingival tissue repair
Lactobacillus paracasei — clinically associated with improved plaque control, reduced acid production, and enhanced oral pH balance
These strains act synergistically to suppress harmful oral bacteria while reinforcing the beneficial species essential for daily protection. Unlike conventional products that mask symptoms, ProDentim restores the oral microbiome from within, promoting long-term comfort and natural defense.
The OwlCore Wellness Research Group validated the clinical potential of these ingredients using referenced sources from PubMed, NIH, and peer-reviewed oral biology journals.
Thousands of verified users across the United States reported consistent results after integrating ProDentim into their daily hygiene routine:
Fresher breath lasting throughout the day, even in chronic halitosis cases
Significant reduction in gum swelling, bleeding, and sensitivity
Fewer new cavities and less visible plaque
Improved gum resilience under stress, sugar intake, and sleep disruption
Increased confidence and oral comfort
These outcomes reinforce the clinical efficacy and public health value of ProDentim as a daily-use probiotic — particularly for individuals seeking natural, stimulant-free solutions to oral inflammation, immune dysregulation, and oral-gut microbial imbalances.
ProDentim represents a new category of functional oral care: targeted, biome-based, and backed by science.
An increasing number of dental professionals in the United States are recommending ProDentim over traditional chemical-based mouthwashes.
Their reasoning is rooted in microbiome science: ProDentim helps restore the natural oral flora rather than disrupt it.
This reflects a broader shift in modern dentistry — from symptom suppression to root-cause, biome-focused interventions that promote lasting oral immune defense.
These endorsements align with our findings from OwlCore Wellness Research Group: practitioners are seeking solutions that are both clinically proven and naturally aligned with the oral ecosystem.
Based on compiled data from our supplement review platform, users typically report:
Breath improvements and reduced gum sensitivity within 7 to 14 days
Noticeable plaque reduction and better oral comfort by day 30
Measurable gains in gum resilience and cavity prevention between 30 to 60 days of consistent daily use
These results reflect the time-dependent adaptation of the oral microbiome to beneficial probiotic strains.
The ProDentim formula was reviewed for:
Allergen-free, stimulant-free, and preservative-free composition
Compatibility with common dental care products
Ease of daily use, requiring only one chewable tablet per day
This simple routine supports high compliance and long-term effectiveness. According to our OwlCore field data, ease of use was a top factor in continued user satisfaction.
Before trying Prodentim, many of these voices felt seen by OwlCore Wellness: in its words, its tone, its integrity. These stories are more than results. They’re proof that when a brand listens, people lean in.
Portland, OR
“The way they explained oral health—not just gums and teeth, but its link to immunity and energy—made me feel truly respected. ProDentim was the next step, but the trust was earned first.”
Savannah, GA
“I return to this health brand because it feels like a sanctuary. Quiet, science-backed, and always centered on care rather than hype.”
Boulder, CO
“An elegant experience: clear guidance rooted in nature and backed by research. ProDentim respects both the microbiome and the whole person.”
| Feature | ProDentim | Conventional Products |
|---|---|---|
| Approach to Microbes | Nurtures beneficial bacteria | Kills all bacteria indiscriminately |
| Key Ingredients | Probiotics, prebiotics, natural antioxidants | Abrasive agents, synthetic chemicals |
| Focus | Long-term oral ecosystem balance | Short-term symptom management |
| Gum and Enamel Support | Strengthens and nourishes | May cause irritation or erosion |
| Systemic Health Impact | Supports immune and systemic health | Limited to oral cavity |
Based on our 2025 supplement review and clinical benchmarks, the OwlCore Wellness Research Group endorses ProDentim as a reliable, science-driven solution for long-term oral health.
Unlike temporary fixes or alcohol-based mouthwashes, ProDentim targets the root causes of oral imbalance — supporting gum immunity, microbiome diversity, and biofilm stability through probiotic action. Its formulation includes strains validated by peer-reviewed research for:
Reducing plaque and gingival inflammation
Enhancing oral immune defense
Promoting breath freshness without synthetic agents
Its once-daily protocol ensures high adherence with no side effects reported across the monitored cohort.
Whether you’re dealing with chronic halitosis, plaque buildup, or just seeking a modern preventive solution, ProDentim represents a safe, research-based option. Backed by scientific data, user-reported outcomes, and our independent analysis, it stands out as a smart health investment — not just for 2025, but for sustained oral and systemic wellness.
If this content sparked a deeper awareness of your oral health, your habits, or your inner balance… that awareness alone is a meaningful first step.
ProDentim represents not a promise, but a shift — grounded in the science of oral flora, supported by daily rituals, and powered by nature’s own beneficial microbes.
Affiliate Disclosure: Some of the links in this post are affiliate links. This means that if you choose to purchase through these links, we may earn a commission at no additional cost to you. Your support helps us continue to bring you honest, research-driven reviews and content.